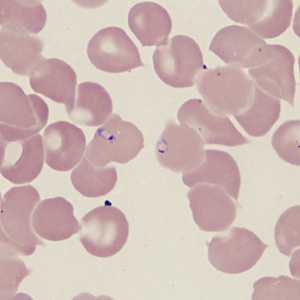
Figure D
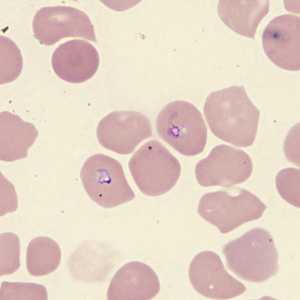
Figure E
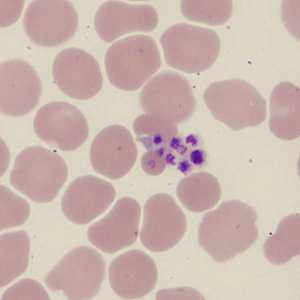
Figure F
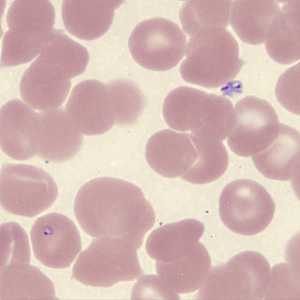
Figure I
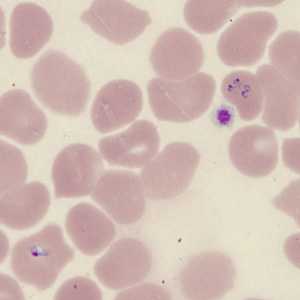
Figure J

Case #431 - November, 2016
A 62-year-old man from Kenya had been living in rural Connecticut with relatives for 6 months when he developed fever, chills, and fatigue. The family took him to their health care provider for medical attention. Blood work-up revealed anemia and blood smears were prepared, stained, and examined. Figures A-I show what was found on thin smears. What is your diagnosis? Based on what criteria?

Figure A

Figure B

Figure C
Figure D
Figure E
Figure F

Figure G

Figure H
Figure I
Figure J
Case Answer
This was a case of babesiosis caused by Babesia sp. Morphologic features included:
- pleomorphic and vacuolated intraerythrocytic ring-like parasites in normal-sized red blood cells.
- extra-erythrocytic presentation of parasites (Figure I).
- an absence of malarial pigment found in Plasmodium species.
Identification of Babesia to the species or strain level is not possible by morphology and requires molecular analysis of a blood specimen. Follow-up on this case included an EDTA blood specimen for PCR and the result was B. microti.
More on: Babesiosis
Images presented in the monthly case studies are from specimens submitted for diagnosis or archiving. On rare occasions, clinical histories given may be partly fictitious.
DPDx is an education resource designed for health professionals and laboratory scientists. For an overview including prevention and control visit www.cdc.gov/parasites/.
- Page last reviewed: December 9, 2016
- Page last updated: December 20, 2016
- Content source:
- Global Health – Division of Parasitic Diseases and Malaria
- Notice: Linking to a non-federal site does not constitute an endorsement by HHS, CDC or any of its employees of the sponsors or the information and products presented on the site.
- Maintained By:


 ShareCompartir
ShareCompartir